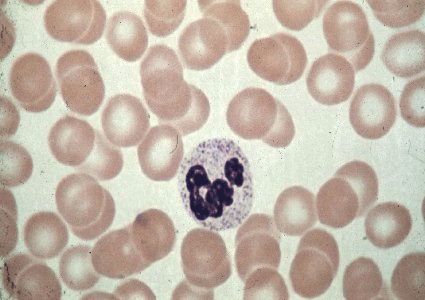
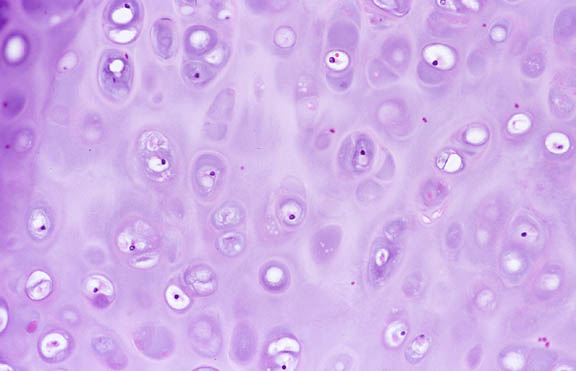

| A | B |
 | Adipose |
 | Areolar |
| Blood |
 | Cardiac |
 | Dense Connective |
 | Elastic Cartilage |
 | Fibrocartilage |
| Hyline Cartilage |
 | Neural Tissue |
 | Neural Tissue |
_Tissue.gif) | Osseous (Bone) |
 | Pseudostratified Epithelium |
 | Simple Columnar Epithelium |
 | Simple Cubiodal Epithelium |
 | Simple Columnar Epithelium |
 | Simple Cubiodal Epithelium |
 | Simple Squamous Epithelium |
 | Skeletal Muscle |
 | Skeletal Muscle |
 | Smooth Muscle |
 | Stratified Squamous Epithelium |
 | Transitional Epithelium |